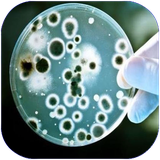
parvaz.olomvafanavryzesty

علوم و فناوری زیستی
مشخصات اصلی برنامه و اطلاعات توسعهدهندهخلاصه بررسی امنیتی




برپایه ۱۰ ضعف شناخته شده براساس OWSAP در برنامههای موبایلی

ضعف امنیتی در پیادهسازی توابع، کارکرد و تنظیمات برنامه

ضعف امنیتی در سرورهای ارتباطی و رابط برنامهنویسی کاربردی

براساس بررسی ۷۴ موتور آنتیویروس در سرویس ویروستوتال
جزئیات بررسی
خلاصه اطلاعات فایل برنامهشدت خطر این آسیبپذیری ۷.۴ از ۱۰ تخمین زده میشود. توضیحات بیشتر در OWSAP-m9 و cwe-312استفاده از اعداد تصادفی بجای رمزنگاری
شدت خطر این آسیبپذیری ۷.۵ از ۱۰ تخمین زده میشود. توضیحات بیشتر در OWSAP-m5 و cwe-330آسیبپذیر در برابر حملات فرد میانی و خطا در SSL
شدت خطر این آسیبپذیری ۷.۴ از ۱۰ تخمین زده میشود. توضیحات بیشتر در OWSAP-m3 و cwe-295استفاده از الگوریتمهای ضعیف برای ایجاد هش
شدت خطر این آسیبپذیری ۷.۴ از ۱۰ تخمین زده میشود. توضیحات بیشتر در OWSAP-m5 و cwe-327ذخیره اطلاعات حساس در حافظه بدون اعمال نظارت روی دسترسیها
شدت خطر این آسیبپذیری ۵.۵ از ۱۰ تخمین زده میشود. توضیحات بیشتر در OWSAP-m2 و cwe-276آسیبپذیری عدم خنثیسازی عناصر مخرب در فرامین SQL
شدت خطر این آسیبپذیری ۵.۹ از ۱۰ تخمین زده میشود. توضیحات بیشتر در OWSAP-m7 و cwe-89امکان اجرای کدهای مخرب در واسط نمایش صفحات وب
شدت خطر این آسیبپذیری ۸.۸ از ۱۰ تخمین زده میشود. توضیحات بیشتر در OWSAP-m1 و cwe-749
